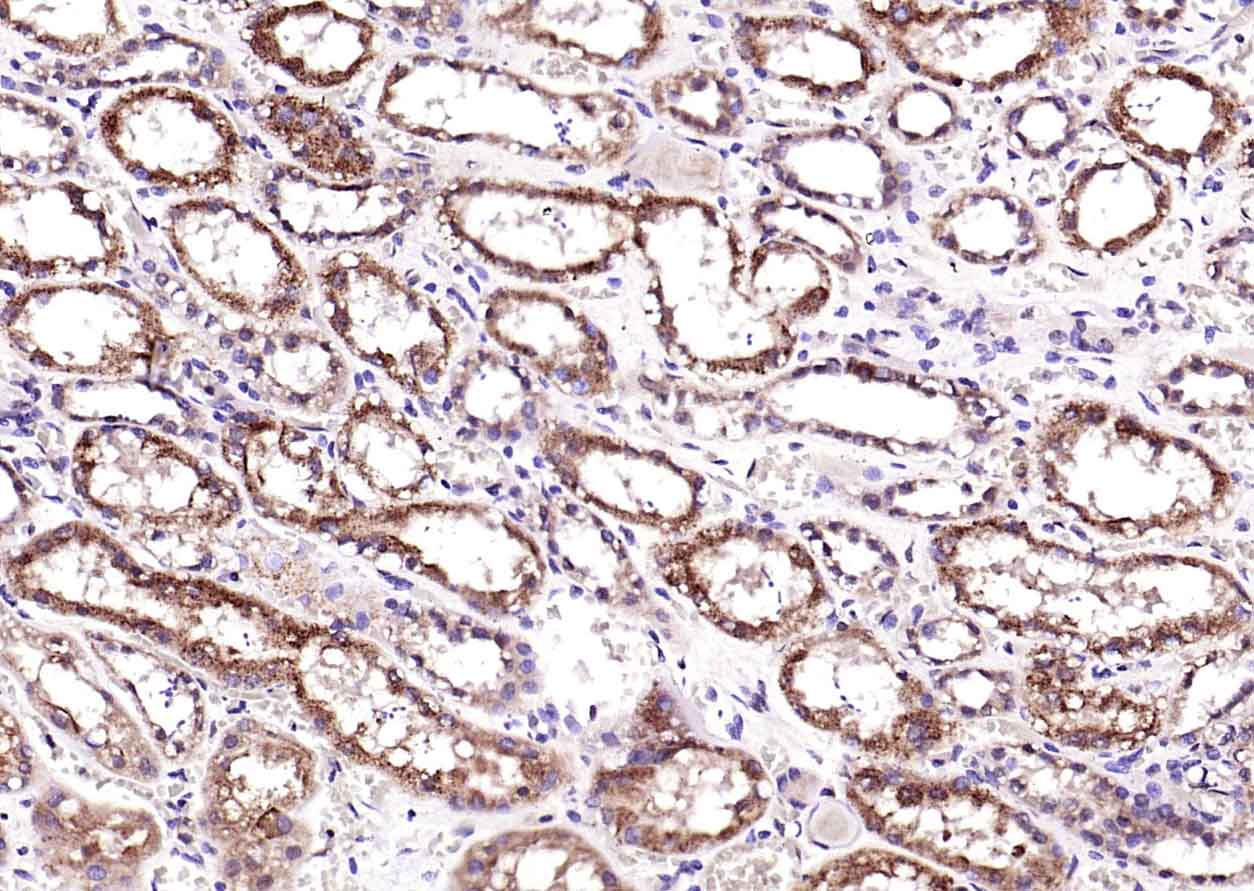
KLK1 Rabbit pAb(bs-1963R)-50ul
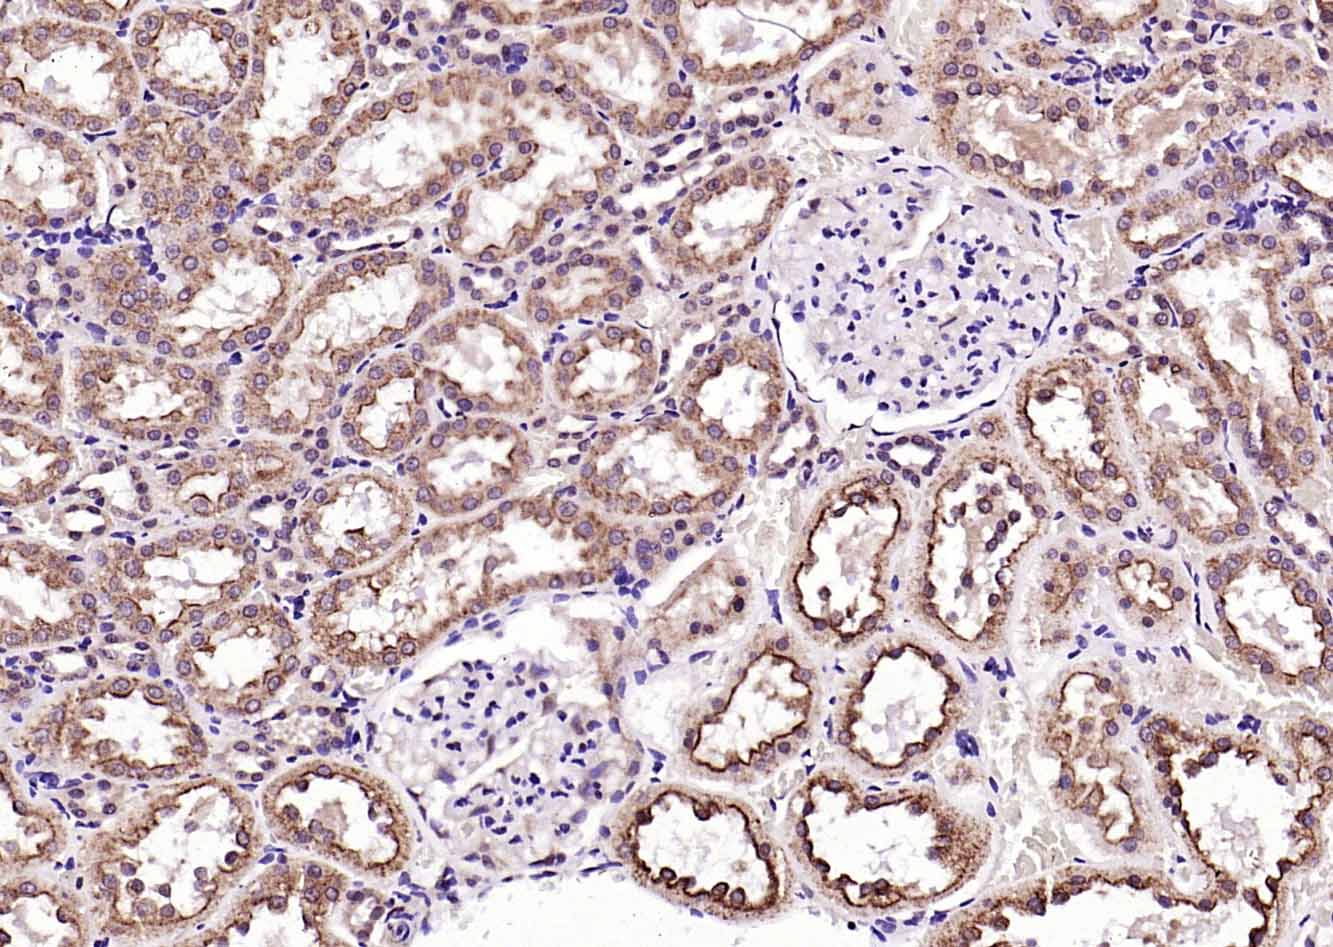
KLK1 Rabbit pAb(bs-1963R)-50ul

相关产品推荐更多 >
万千商家帮你免费找货
0 人在求购买到急需产品
- 详细信息
- 文献和实验
- 技术资料
- 应用范围:
产品信息以Bioss网站为准
- 规格:
50ul/100ul/200ul
| 规格: | 50ul | 产品价格: | ¥1180.0 |
|---|---|---|---|
| 规格: | 100ul | 产品价格: | ¥1980.0 |
| 规格: | 200ul | 产品价格: | ¥2800.0 |
| 产品编号 | bs-1963R |
| 英文名称 | KLK1 Rabbit pAb |
| 中文名称 | 激肽释放酶1抗体 |
| 英文别名 | Kallikrein 1; Kallikrein-1; hK1; Klk6; KLKR; Glandular kallikrein 1; hK 1; Kallikrein serine protease 1; Kidney/pancreas/salivary gland kallikrein; Klk 6; Tissue kallikrein; Klk1b3; Klk1c1; Ngfg; rGK-1; preprokallikrein; KLK1_HUMAN. |
| 产品应用 | WB=1:500-2000, IHC-P=1:100-500, IHC-F=1:100-500, IF=1:100-500 Not yet tested in other applications. |
| 交叉反应 | Human, Mouse, Rat (Dog, Pig, Horse, Rabbit) |
| 抗体来源 | Rabbit |
| 免疫原 | KLH conjugated synthetic peptide derived from human KLK1 |
| 亚型 | IgG |
| 性状 | Liquid |
| 纯化方法 | affinity purified by Protein A |
| 克隆类型 | Polyclonal |
| 理论分子量 | 26 kDa |
| 浓度 | 1mg/ml |
| 储存液 | 0.01M TBS (pH7.4) with 1% BSA, 0.02% Proclin300 and 50% Glycerol. |
| 研究领域 | Cancer > Invasion/microenvironment > Angiogenesis > ECM enzymes > Kallikreins Cancer > Invasion/microenvironment > ECM > Extracellular matrix > Kallikreins Cardiovascular > Blood > Coagulation > Intrinsic Cardiovascular > Blood > Serum Proteins Cell Biology > Proteolysis / Ubiquitin > Proteolytic enzymes Cell Biology > Proteolysis / Ubiquitin > Proteolytic enzymes > Serine protease > Kallikreins Signal Transduction > Cytoskeleton / ECM > Extracellular Matrix > ECM Enzymes > Kallikreins |
| 组织特异性 | Isoform 2 is expressed in pancreas, salivary glands, kidney, colon, prostate gland, testis, spleen and the colon adenocarcinoma cell line T84. |
| 翻译后修饰 | The O-linked polysaccharides on Ser-93, Ser-104 and Ser-167 are probably the mucin type linked to GalNAc. In PubMed:3163150, GalNAc was detected with the corresponding peptides but not located. |
| 相似性 | Belongs to the peptidase S1 family. Kallikrein subfamily. Contains 1 peptidase S1 domain. |
| 功能 | Glandular kallikreins cleave Met-Lys and Arg-Ser bonds in kininogen to release Lys-bradykinin. |
| 保存条件 | Shipped at 4℃. Store at -20℃ for one year. Avoid repeated freeze/thaw cycles. |
| 注意事项 | This product as supplied is intended for research use only, not for use in human, therapeutic or diagnostic applications. |
| 背景资料 | Kallikreins are a subgroup of serine proteases having diverse physiological functions. Growing evidence suggests that many kallikreins are implicated in carcinogenesis and some have potential as novel cancer and other disease biomarkers. This gene is one of the fifteen kallikrein subfamily members located in a cluster on chromosome 19. This protein is functionally conserved in its capacity to release the vasoactive peptide, Lys-bradykinin, from low molecular weight kininogen. [provided by RefSeq, Jul 2008] |
| 应用 | 推荐稀释比例 |
| {WB} | {1:500-2000} |
| {IHC-P} | {1:100-500} |
| {IHC-F} | {1:100-500} |
| {IF} | {1:100-500} |

Lane 1: Human K562 cell lysates
Lane 2: Human SW480 cell lysates
Primary: Anti-KLK1 (bs-1963R) at 1/1000 dilution
Secondary: IRDye800CW Goat Anti-Rabbit IgG at 1/20000 dilution
Predicted band size: 26 kD
Observed band size: 30 kD

风险提示:丁香通仅作为第三方平台,为商家信息发布提供平台空间。用户咨询产品时请注意保护个人信息及财产安全,合理判断,谨慎选购商品,商家和用户对交易行为负责。对于医疗器械类产品,请先查证核实企业经营资质和医疗器械产品注册证情况。
文献和实验[IF={{ 0 }}] {Morrison MD et al. Identifying Candidate Biomarkers for Pleomorphic Adenoma: A Case-Control Study. Head Neck Pathol. 2019 Sep;13(3):286-297. } {IHC} {Human}
技术资料暂无技术资料 索取技术资料








